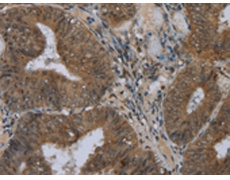
一抗

中文名稱: 兔抗NAT10多克隆抗體
英文名稱: Anti-NAT10 rabbit polyclonal antibody
別 名: ALP; NET43
相關(guān)類別: 一抗
儲(chǔ) 存: 冷凍(-20℃)
宿 主: Rabbit
抗 原: NAT10
反應(yīng)種屬: Human, Mouse
標(biāo) 記 物: Unconjugate
克隆類型: rabbit polyclonal
技術(shù)規(guī)格
|
Background: |
N-acetyltransferase 10 is an enzyme that in humans is encoded by the NAT10 gene. Has protein acetyltransferase activity in vitro. Can acetylate both histones and microtubules. Histone acetylation may regulate transcription and mitotic chromosome de-condensation. Activates telomerase activity by stimulating the transcription of TERT, and may also regulate telomerase function by affecting the balance of telomerase subunit assembly, disassembly, and localization. |
|
Applications: |
ELISA, WB, IHC |
|
Name of antibody: |
NAT10 |
|
Immunogen: |
Fusion protein of human NAT10 |
|
Full name: |
N-acetyltransferase 10 (GCN5-related) |
|
Synonyms: |
ALP; NET43 |
|
SwissProt: |
Q9H0A0 |
|
ELISA Recommended dilution: |
2000-5000 |
|
IHC positive control: |
Human colon cancer and human thyroid cancer |
|
IHC Recommend dilution: |
50-200 |
|
WB Predicted band size: |
116 kDa |
|
WB Positive control: |
A549, K562 and hela cells |
|
WB Recommended dilution: |
500-2000 |


 購(gòu)物車
購(gòu)物車 幫助
幫助
 021-54845833/15800441009
021-54845833/15800441009